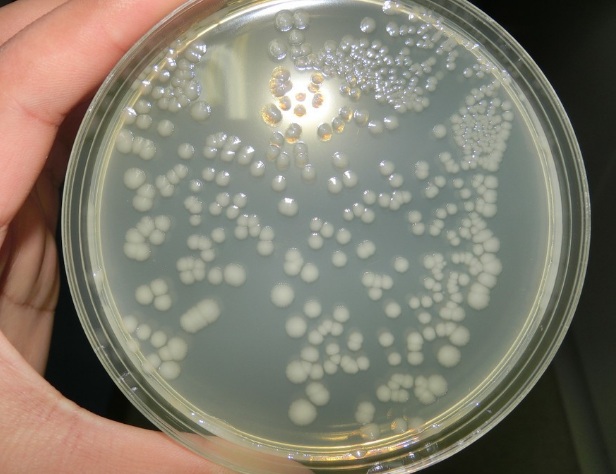

相关文章
-

抗生素微生物检定用器具的清洗和灭菌标准操作
不锈钢管: 1.1 钢管用过后,用1:1000新洁尔灭溶液浸泡过夜,用绸布内外串擦。 1.2 然后,置于75%乙醇中浸泡至少12小时,取出,用纯化水冲洗沥干。 1.3 置烘箱中在160℃干热灭菌2小时
作者:admin , 发布于2019年05月12日 -

药品不良反应监察报告制度
1 质量技术部是负责处理药品不良反应的专门机构,质量技术部指定人员处理该项工作。 2 用户有药品不良反应投诉,要及时了解情况,必要时上报主管领导,会同技术人员直赴现场调查
作者:admin , 发布于2019年04月07日